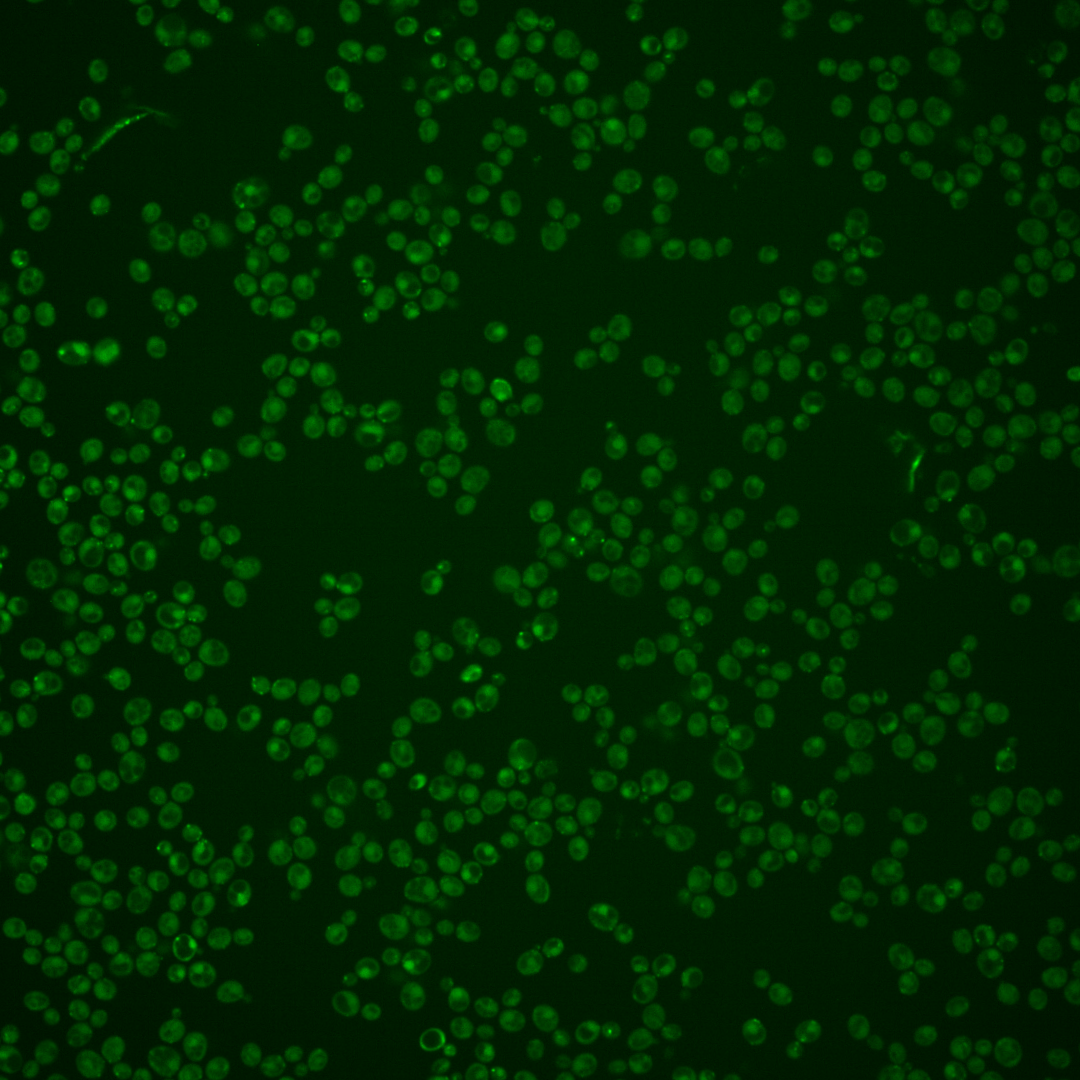
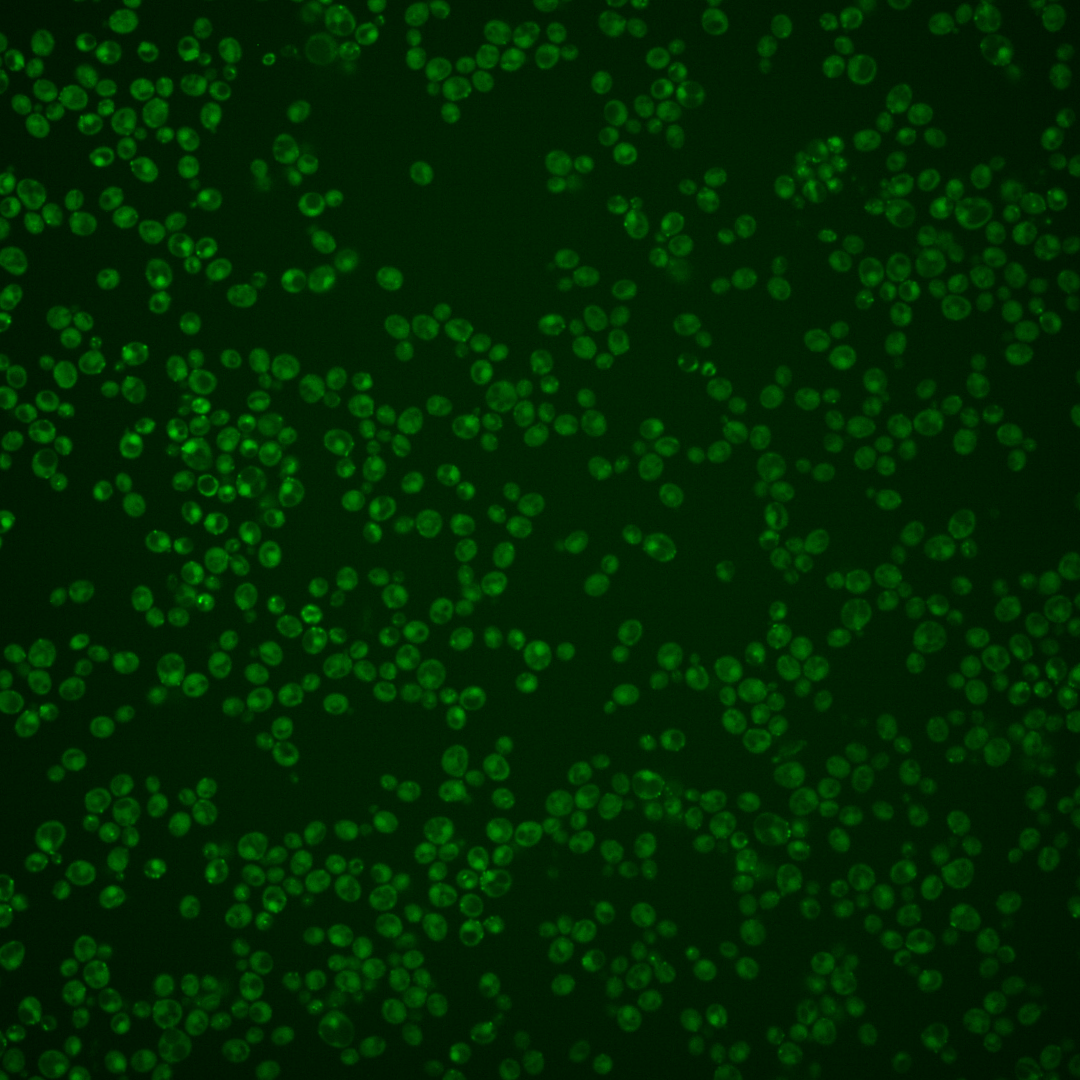
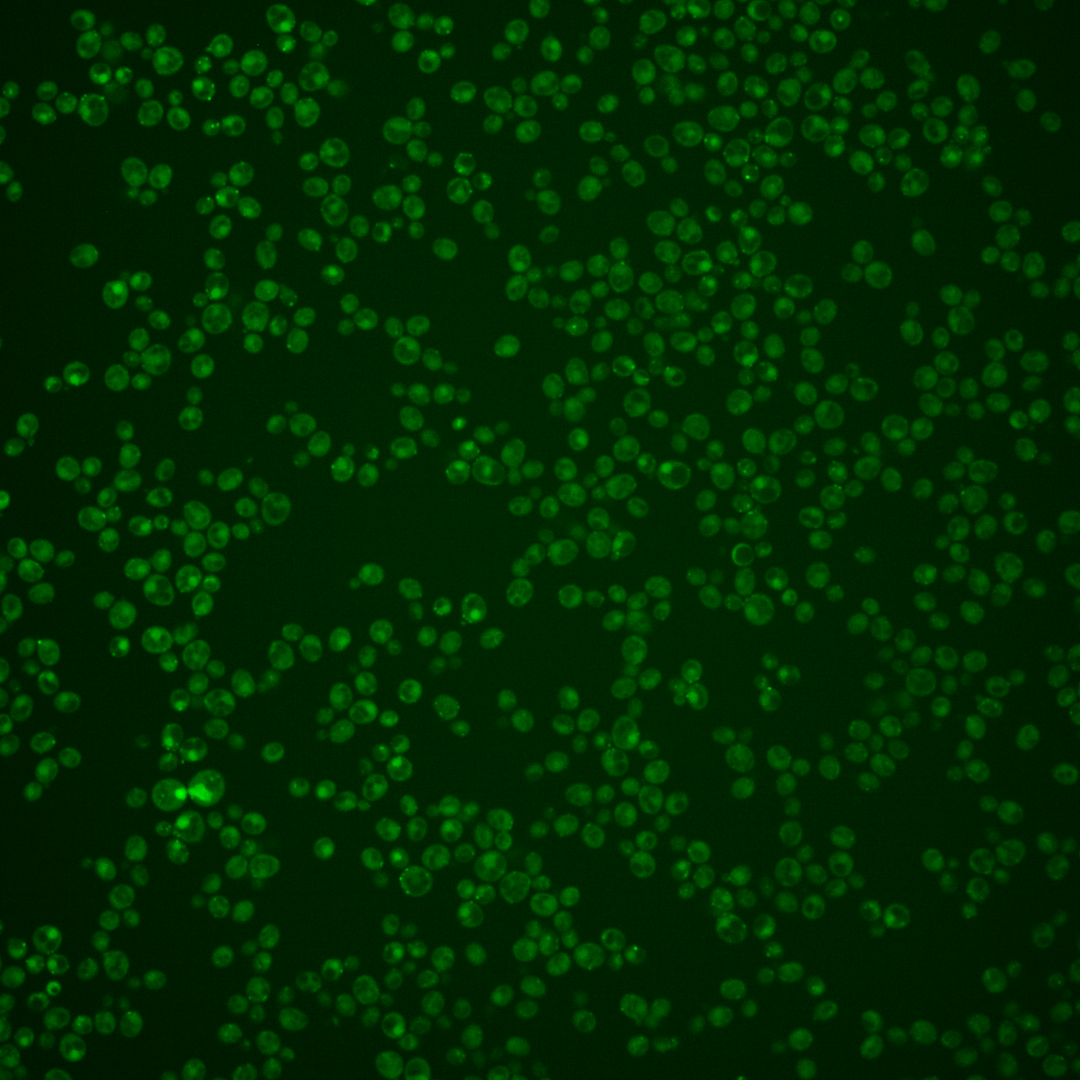

| Standard name | |
|---|---|
| Human Ortholog | |
| Description | Peroxisomal ubiquitin conjugating enzyme; required for peroxisomal matrix protein import and peroxisome biogenesis |
Micrographs




















































































Sub-cellular Localization
Yeast GFP Assignment
Protein Abundance
Localization Change
External localization resources
| ensLOC | DeepLoc | |||||||||||||||||||||||
|---|---|---|---|---|---|---|---|---|---|---|---|---|---|---|---|---|---|---|---|---|---|---|---|---|
| Localization | WT1 | WT2 | WT3 | RAP60 | RAP140 | RAP220 | RAP300 | RAP380 | RAP460 | RAP540 | RAP620 | RAP700 | HU80 | HU120 | HU160 | rpd3Δ_1 | rpd3Δ_2 | rpd3Δ_3 | WT1 | WT2 | WT3 | AF100 | AF140 | AF180 |
| Cortical Patches | 2 | 8 | 2 | 2 | 0 | 7 | 1 | 0 | 0 | 0 | 0 | 2 | 50 | 27 | 23 | 6 | 4 | 13 | 20 | 30 | 19 | 26 | 60 | 83 |
| Bud | 11 | 12 | 27 | 31 | 61 | 72 | 73 | 93 | 61 | 55 | 52 | 73 | 17 | 14 | 29 | 43 | 39 | 33 | 4 | 7 | 3 | 7 | 7 | 12 |
| Bud Neck | 14 | 2 | 9 | 4 | 8 | 9 | 13 | 16 | 4 | 5 | 4 | 2 | 30 | 20 | 22 | 10 | 12 | 7 | 7 | 9 | 4 | 15 | 17 | 15 |
| Bud Site | 8 | 2 | 6 | 10 | 11 | 31 | 38 | 29 | 14 | 6 | 13 | 14 | 9 | 7 | 4 | 10 | 16 | 22 | – | – | – | – | – | – |
| Cell Periphery | 1 | 0 | 0 | 0 | 0 | 0 | 3 | 0 | 0 | 1 | 1 | 3 | 3 | 0 | 1 | 0 | 0 | 0 | 0 | 1 | 0 | 2 | 1 | 7 |
| Cytoplasm | 99 | 70 | 34 | 72 | 102 | 131 | 163 | 219 | 134 | 197 | 129 | 179 | 125 | 175 | 212 | 40 | 31 | 38 | 31 | 25 | 5 | 18 | 42 | 53 |
| Endoplasmic Reticulum | 1 | 4 | 2 | 3 | 0 | 1 | 0 | 3 | 0 | 0 | 0 | 1 | 4 | 4 | 10 | 3 | 10 | 5 | 0 | 1 | 0 | 2 | 3 | 2 |
| Endosome | 13 | 12 | 3 | 13 | 41 | 7 | 10 | 20 | 6 | 9 | 2 | 4 | 8 | 21 | 61 | 84 | 82 | 85 | 45 | 42 | 38 | 43 | 66 | 50 |
| Golgi | 1 | 1 | 0 | 0 | 0 | 0 | 0 | 0 | 0 | 0 | 0 | 0 | 0 | 0 | 0 | 6 | 6 | 4 | 2 | 4 | 0 | 3 | 2 | 4 |
| Mitochondria | 35 | 33 | 43 | 78 | 147 | 293 | 373 | 375 | 281 | 286 | 286 | 388 | 6 | 1 | 3 | 70 | 32 | 48 | 53 | 55 | 29 | 64 | 93 | 99 |
| Nucleus | 0 | 0 | 0 | 1 | 2 | 4 | 4 | 4 | 2 | 1 | 1 | 1 | 0 | 0 | 0 | 7 | 5 | 9 | 0 | 0 | 0 | 0 | 0 | 0 |
| Nuclear Periphery | 0 | 0 | 1 | 0 | 0 | 0 | 1 | 1 | 0 | 1 | 0 | 0 | 0 | 0 | 0 | 4 | 4 | 2 | 0 | 0 | 0 | 0 | 0 | 0 |
| Nucleolus | 0 | 0 | 2 | 2 | 0 | 2 | 5 | 3 | 2 | 2 | 0 | 0 | 1 | 0 | 2 | 15 | 10 | 11 | 0 | 1 | 0 | 1 | 0 | 0 |
| Peroxisomes | 14 | 34 | 35 | 94 | 144 | 78 | 85 | 80 | 34 | 38 | 23 | 42 | 24 | 63 | 71 | 115 | 154 | 169 | 80 | 46 | 94 | 86 | 128 | 130 |
| SpindlePole | 71 | 17 | 45 | 71 | 128 | 114 | 162 | 206 | 87 | 122 | 45 | 70 | 113 | 168 | 182 | 195 | 175 | 209 | 31 | 23 | 17 | 18 | 38 | 23 |
| Vac/Vac Membrane | 1 | 2 | 1 | 1 | 1 | 2 | 2 | 5 | 5 | 4 | 5 | 1 | 1 | 1 | 4 | 3 | 5 | 3 | 4 | 3 | 1 | 4 | 10 | 14 |
| Unique Cell Count | 221 | 166 | 159 | 277 | 433 | 510 | 672 | 774 | 452 | 536 | 412 | 570 | 313 | 417 | 510 | 426 | 416 | 432 | 287 | 258 | 217 | 297 | 482 | 505 |
| Labelled Cell Count | 271 | 197 | 210 | 382 | 645 | 751 | 933 | 1054 | 630 | 727 | 561 | 780 | 391 | 501 | 624 | 611 | 585 | 658 | 287 | 258 | 217 | 297 | 482 | 505 |
Yeast GFP Assignment
Protein Abundance
| Screen | WT1 | WT2 | WT3 | RAP60 | RAP140 | RAP220 | RAP300 | RAP380 | RAP460 | RAP540 | RAP620 | RAP700 | HU80 | HU120 | HU160 | rpd3Δ_1 | rpd3Δ_2 | rpd3Δ_3 | AF100 | AF140 | AF180 |
|---|---|---|---|---|---|---|---|---|---|---|---|---|---|---|---|---|---|---|---|---|---|
| Mean Cell GFP Intensity (1e-4) | 4.1 | 4.5 | 3.9 | 3.6 | 3.5 | 3.4 | 2.9 | 3.2 | 2.9 | 2.8 | 2.8 | 2.9 | 5.1 | 5.0 | 5.1 | 5.5 | 5.6 | 5.6 | 5.6 | 5.4 | 5.4 |
| Std Deviation (1e-4) | 1.1 | 0.9 | 1.0 | 1.1 | 1.5 | 1.3 | 1.0 | 1.2 | 1.1 | 1.0 | 0.8 | 0.7 | 0.7 | 0.8 | 0.9 | 1.1 | 1.2 | 1.3 | 1.5 | 1.3 | 1.4 |
| Intensity Change (Log2) | – | – | – | -0.1 | -0.12 | -0.17 | -0.43 | -0.28 | -0.4 | -0.44 | -0.46 | -0.42 | 0.39 | 0.38 | 0.39 | 0.51 | 0.53 | 0.52 | 0.53 | 0.48 | 0.48 |
Localization Change
| Localization | RAP60 | RAP140 | RAP220 | RAP300 | RAP380 | RAP460 | RAP540 | RAP620 | RAP700 | HU80 | HU120 | HU160 | rpd3Δ_1 | rpd3Δ_2 | rpd3Δ_3 |
|---|---|---|---|---|---|---|---|---|---|---|---|---|---|---|---|
| Actin | – | – | – | – | – | – | – | – | – | – | – | – | – | – | – |
| Bud | – | – | – | – | – | – | – | – | – | – | – | – | – | – | – |
| Bud Neck | – | – | – | – | – | – | – | – | – | – | – | – | – | – | – |
| Bud Site | – | – | – | – | – | – | – | – | – | – | – | – | – | – | – |
| Cell Periphery | – | – | – | – | – | – | – | – | – | – | – | – | – | – | – |
| Cyto | – | – | – | – | – | – | – | – | – | – | – | – | – | – | – |
| Endoplasmic Reticulum | – | – | – | – | – | – | – | – | – | – | – | – | – | – | – |
| Endosome | – | – | – | – | – | – | – | – | – | – | – | – | – | – | – |
| Golgi | – | – | – | – | – | – | – | – | – | – | – | – | – | – | – |
| Mitochondria | – | – | – | – | – | – | – | – | – | – | – | – | – | – | – |
| Nuclear Periphery | – | – | – | – | – | – | – | – | – | – | – | – | – | – | – |
| Nuc | – | – | – | – | – | – | – | – | – | – | – | – | – | – | – |
| Nucleolus | – | – | – | – | – | – | – | – | – | – | – | – | – | – | – |
| Peroxisomes | – | – | – | – | – | – | – | – | – | – | – | – | – | – | – |
| SpindlePole | – | – | – | – | – | – | – | – | – | – | – | – | – | – | – |
| Vac | – | – | – | – | – | – | – | – | – | – | – | – | – | – | – |
| Cortical Patches | – | – | – | – | – | – | – | – | – | – | – | – | – | – | – |
| Cytoplasm | – | – | – | – | – | – | – | – | – | – | – | – | – | – | – |
| Nucleus | – | – | – | – | – | – | – | – | – | – | – | – | – | – | – |
| Vacuole | – | – | – | – | – | – | – | – | – | – | – | – | – | – | – |
External localization resources
Images






























Protein Concentration and Protein Localization Data
| R1 | R2 | R3 | ||||||||||||||||
|---|---|---|---|---|---|---|---|---|---|---|---|---|---|---|---|---|---|---|
| G1 Pre-START | G1 Post-START | S/G2 | Metaphase | Anaphase | Telophase | G1 Pre-START | G1 Post-START | S/G2 | Metaphase | Anaphase | Telophase | G1 Pre-START | G1 Post-START | S/G2 | Metaphase | Anaphase | Telophase | |
| Concentration | 0.9372 | 0.0806 | 1.0461 | 0.8222 | 0.4207 | 0.43 | 0.1753 | 0.8683 | 0.8285 | 0.5741 | 1.1143 | 0.9494 | -1.2809 | -0.8634 | -1.2629 | -1.1838 | -1.4111 | -1.0747 |
| Actin | 0.0725 | 0.0468 | 0.0482 | 0.0132 | 0.0156 | 0.0083 | 0.0395 | 0.0225 | 0.0275 | 0.0092 | 0.0264 | 0.0113 | 0.0506 | 0.0154 | 0.0218 | 0.0028 | 0.0101 | 0.0174 |
| Bud | 0.001 | 0.0035 | 0.0032 | 0.0014 | 0.0021 | 0.0008 | 0.0008 | 0.0025 | 0.0033 | 0.0016 | 0.0002 | 0.0003 | 0.0003 | 0.0013 | 0.0008 | 0.0002 | 0.0001 | 0.0002 |
| Bud Neck | 0.0071 | 0.0016 | 0.0167 | 0.0379 | 0.0387 | 0.0147 | 0.0149 | 0.0146 | 0.029 | 0.0056 | 0.0025 | 0.0225 | 0.0058 | 0.0093 | 0.0356 | 0.0032 | 0.0027 | 0.0111 |
| Bud Periphery | 0.0017 | 0.0099 | 0.0049 | 0.0039 | 0.0044 | 0.0024 | 0.002 | 0.0052 | 0.01 | 0.006 | 0.0004 | 0.0009 | 0.0006 | 0.0019 | 0.0018 | 0.0003 | 0.0003 | 0.0005 |
| Bud Site | 0.0132 | 0.0223 | 0.0366 | 0.0012 | 0.0096 | 0.0024 | 0.0048 | 0.0423 | 0.0147 | 0.0169 | 0.0011 | 0.0018 | 0.0088 | 0.0459 | 0.0223 | 0.0006 | 0.0014 | 0.0004 |
| Cell Periphery | 0.0011 | 0.0006 | 0.0006 | 0.0002 | 0.0005 | 0.0005 | 0.0008 | 0.0011 | 0.0009 | 0.0027 | 0.0001 | 0.0005 | 0.0007 | 0.0008 | 0.0005 | 0 | 0.0003 | 0.0002 |
| Cytoplasm | 0.0121 | 0.0258 | 0.0231 | 0.0131 | 0.0088 | 0.0228 | 0.0219 | 0.0304 | 0.019 | 0.0109 | 0.0039 | 0.0287 | 0.0254 | 0.0558 | 0.0275 | 0.0106 | 0.0285 | 0.0337 |
| Cytoplasmic Foci | 0.2321 | 0.1881 | 0.1516 | 0.1675 | 0.2139 | 0.303 | 0.2843 | 0.2292 | 0.2205 | 0.217 | 0.2782 | 0.3193 | 0.3331 | 0.318 | 0.3149 | 0.4201 | 0.3282 | 0.3943 |
| Eisosomes | 0.0012 | 0.0003 | 0.0005 | 0.0004 | 0.0002 | 0.0003 | 0.0021 | 0.0012 | 0.0016 | 0.0015 | 0.001 | 0.0006 | 0.0009 | 0.0007 | 0.0005 | 0.0001 | 0.0003 | 0.0003 |
| Endoplasmic Reticulum | 0.0027 | 0.0007 | 0.0013 | 0.0006 | 0.0005 | 0.0009 | 0.0021 | 0.0005 | 0.0009 | 0.0003 | 0.0006 | 0.0005 | 0.0027 | 0.0017 | 0.0007 | 0.0003 | 0.0008 | 0.001 |
| Endosome | 0.0772 | 0.0162 | 0.0352 | 0.0256 | 0.0264 | 0.0301 | 0.019 | 0.0307 | 0.032 | 0.0549 | 0.0183 | 0.0221 | 0.0358 | 0.0419 | 0.0308 | 0.0392 | 0.0574 | 0.0269 |
| Golgi | 0.0243 | 0.007 | 0.0163 | 0.0254 | 0.0442 | 0.0074 | 0.0112 | 0.0063 | 0.0107 | 0.0193 | 0.0067 | 0.0073 | 0.0098 | 0.0107 | 0.0114 | 0.0157 | 0.0138 | 0.0097 |
| Lipid Particles | 0.0494 | 0.0307 | 0.0159 | 0.0142 | 0.0172 | 0.046 | 0.0244 | 0.0234 | 0.0221 | 0.0562 | 0.0478 | 0.0445 | 0.0688 | 0.0256 | 0.0164 | 0.0449 | 0.102 | 0.0379 |
| Mitochondria | 0.0106 | 0.0048 | 0.0334 | 0.0052 | 0.0069 | 0.0155 | 0.0045 | 0.0128 | 0.016 | 0.026 | 0.0095 | 0.0113 | 0.005 | 0.0056 | 0.0136 | 0.0056 | 0.0028 | 0.0065 |
| None | 0.124 | 0.2373 | 0.1763 | 0.2629 | 0.044 | 0.2008 | 0.2626 | 0.3401 | 0.3361 | 0.1204 | 0.1997 | 0.2182 | 0.1968 | 0.2727 | 0.2227 | 0.0908 | 0.0894 | 0.1228 |
| Nuclear Periphery | 0.0036 | 0.0005 | 0.0051 | 0.0008 | 0.0034 | 0.0038 | 0.0065 | 0.0002 | 0.0006 | 0.0001 | 0.0045 | 0.0008 | 0.0036 | 0.0008 | 0.0004 | 0.0003 | 0.0002 | 0.0028 |
| Nucleolus | 0.004 | 0.0015 | 0.0017 | 0.0042 | 0.0016 | 0.0029 | 0.0017 | 0.0008 | 0.0015 | 0.0011 | 0.0045 | 0.0009 | 0.0039 | 0.0012 | 0.0009 | 0.0002 | 0.0003 | 0.0002 |
| Nucleus | 0.0035 | 0.0015 | 0.0031 | 0.0023 | 0.0025 | 0.002 | 0.0077 | 0.0005 | 0.0008 | 0.0006 | 0.0184 | 0.0006 | 0.0037 | 0.0011 | 0.0007 | 0.0002 | 0.0002 | 0.0006 |
| Peroxisomes | 0.313 | 0.3729 | 0.4072 | 0.3807 | 0.5371 | 0.316 | 0.2825 | 0.2315 | 0.2451 | 0.4249 | 0.3389 | 0.2773 | 0.235 | 0.1796 | 0.2625 | 0.3613 | 0.3526 | 0.3285 |
| Punctate Nuclear | 0.0324 | 0.0265 | 0.0131 | 0.0376 | 0.0209 | 0.0155 | 0.0048 | 0.0029 | 0.0057 | 0.0205 | 0.0359 | 0.0287 | 0.0043 | 0.0063 | 0.0126 | 0.0028 | 0.0063 | 0.004 |
| Vacuole | 0.0107 | 0.0015 | 0.0048 | 0.0013 | 0.001 | 0.0031 | 0.0017 | 0.0011 | 0.0016 | 0.0037 | 0.0009 | 0.0017 | 0.0038 | 0.003 | 0.0013 | 0.0006 | 0.0021 | 0.0006 |
| Vacuole Periphery | 0.0027 | 0.0003 | 0.0012 | 0.0004 | 0.0003 | 0.0008 | 0.0005 | 0.0002 | 0.0004 | 0.0008 | 0.0005 | 0.0003 | 0.0006 | 0.0005 | 0.0003 | 0.0002 | 0.0002 | 0.0003 |
Sequencing Data
| R1 | R2 | |||||||||
|---|---|---|---|---|---|---|---|---|---|---|
| G1 Post-START | S/G2 | Metaphase | Anaphase | Telophase | G1 Post-START | S/G2 | Metaphase | Anaphase | Telophase | |
| Gene Expression | 14.9919 | 3.5738 | 6.6298 | 11.8526 | 19.4377 | 5.9934 | 15.3573 | 18.2915 | 10.8211 | 12.0088 |
| Translational Efficiency | 1.1054 | 4.2479 | 1.962 | 0.8311 | 0.5492 | 2.7357 | 1.3685 | 0.8213 | 1.6144 | 1.3215 |
Hit Data
| Dataset | Hit |
|---|---|
| Protein Concentration | ✘ |
| Protein Localization | ✘ |
| Gene Expression | ✘ |
| Translational Efficiency | ✘ |
Endocytosis
| Temp | Actin Patch (Sac6-tdTomato) | Cortical Patch (Sla1-GFP) | Late Endosome (Snf7-GFP) | Vacuole (Vph1-GFP) |
|---|---|---|---|---|
| 37℃ | ||||
| RT |
Cell Cycle Omics
CYCLoPs (Pex4-GFP)
| Gene / Allele | Actin Patch (Sac6-tdTomato) | Cortical Patch (Sla1-GFP) | Late Endosome (Snf7-GFP) | Vacuole (Sac6-tdTomato) |
|---|
| Gene | Images |
|---|
| Gene | Images |
|---|
Images are not yet available
Images are not yet available